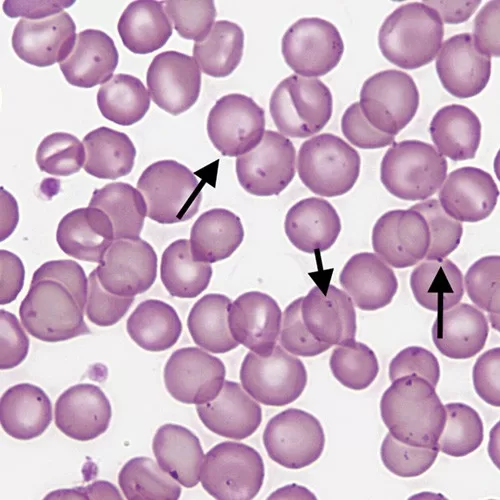

Hemotropic mycoplasmas, also known as hemoplasmas, represent a group of small, cell-wall deficient bacteria that attach to red blood cells, posing significant health risks, especially in immunosuppressed patients. These pathogens can lead to severe conditions such as hemolytic anemia, which is particularly concerning in vulnerable populations, including individuals with weakened immune systems. Recent studies have highlighted the zoonotic potential of hemotropic mycoplasmas, with infections documented in pediatric patients who have received solid organ or stem cell transplants. Moreover, evidence indicates that these infections may be linked to bat-transmitted infections, given their genetic similarities to strains found in bat species like Miniopterus schreibersii. As our understanding of zoonotic diseases continues to evolve, the use of advanced molecular techniques, such as real-time PCR in diagnostics, becomes crucial for timely and effective disease management.
Mycoplasma infections, particularly those of the hemotropic variety, encompass a range of small bacteria that lack a cell wall and are adept at attaching to erythrocytes. These microorganisms often emerge as opportunistic pathogens in immunocompromised hosts, leading to conditions such as hemolytic anemia. In recent observations, cases of mycoplasma infections have been reported following zoonotic transmission, indicating a potential public health risk, especially among individuals with weakened immune systems. Furthermore, the discovery of bacterial strains in bat populations underscores the complexities of veterinary and human medicine intersections. Understanding the implications of these pathogens, particularly in a diagnostic context using methods like real-time PCR, is essential for addressing the challenges they pose in both pediatric and adult populations.
Understanding Hemotropic Mycoplasmas and Their Implications
Hemotropic mycoplasmas, often referred to as hemoplasmas, are a unique group of cell-wall deficient bacteria that primarily attach themselves to the surface of red blood cells (erythrocytes). These bacteria can be particularly problematic in immunocompromised patients, as their presence can lead to significant health issues, including hemolytic anemia. In pediatric patients, especially those with weakened immune systems due to solid organ transplants or cancer treatments, the exposure to these pathogens poses a serious risk. Understanding their impact is crucial, especially given the rising concerns of zoonotic diseases and the transmission dynamics involved.
The implications of hemotropic mycoplasmas extend beyond mere infection; they involve complex interactions with the host’s immune response, particularly in pediatric populations. Immunosuppressed individuals are more susceptible to the adverse effects of hemoplasmas, which can stimulate an immune response that varies significantly from healthy patients. Furthermore, the identification of specific strains matching those found in bats indicates a potential wildlife reservoir for these pathogens and raises vital questions about transmission routes and preventive measures.
Zoonotic Transmission and Its Significance
The detection of hemotropic mycoplasmas in immunosuppressed pediatric patients underscores the alarming potential for zoonotic transmission. Previous studies have shown that certain strains, specifically those linked to bat populations, can pose a threat to human health when exposure occurs. This concern is particularly relevant for individuals like solid organ transplant recipients, who may not only be at increased risk for opportunistic infections but also face heightened vulnerability to zoonotic diseases transmitted from companion animals or wildlife.
Investigating the zoonotic potential of these pathogens is crucial, especially in urban environments where pet ownership is prevalent. The study in question emphasized that despite the documented presence of hemoplasmas in bats, no direct evidence of zoonotic transfer to pets was observed in this cohort of immunocompromised children. However, the potential risks suggest the need for ongoing surveillance and research to understand domestic reservoirs or vectors that could facilitate such transmission. This knowledge is essential for developing prevention strategies to protect vulnerable populations.
Role of Real-Time PCR in Diagnosing Hemoplasmas
Real-time PCR serves as a vital tool in the diagnosis of hemotropic mycoplasmas, particularly when dealing with immunosuppressed patients. The ability to amplify specific genetic material corresponding to hemoplasma species allows for rapid and accurate detection, which is critical when timely treatment is needed to prevent complications such as hemolytic anemia. In this study, the use of real-time PCR targeting the hemoplasma 16S rRNA gene yielded positive results in immunocompromised children, illuminating the potential for these infections to be overlooked in clinical settings.
Beyond mere detection, real-time PCR enhances our understanding of the epidemiology of hemoplasmas, especially in pediatric populations. By confirming the presence of specific strains and identifying sources of infection, researchers can dissect the complexities of zoonotic transmission and its implications on public health. For healthcare providers, integrating real-time PCR into diagnostic protocols plays a significant role in identifying at-risk patients and implementing necessary preventive measures.
Clinical Manifestations of Hemoplasma Infections
Clinical manifestations of hemotropic mycoplasma infections can be diverse and often mimic other infectious diseases, complicating the diagnostic process in immunocompromised patients. Commonly reported symptoms include anemia, fever, and asthenia, which may indicate an underlying hemoplasma infection or a reaction due to their presence. The multifaceted nature of these clinical signs necessitates a high index of suspicion among healthcare providers when dealing with patients who have undergone procedures such as organ transplants or chemotherapy.
Understanding the breadth of symptoms associated with hemoplasma infections is not only essential for accurate diagnosis but also for managing the overall health of immunosuppressed individuals. Variability in clinical presentation can delay treatment and lead to heightened morbidity. Therefore, increased awareness and knowledge about hemoplasmas can improve outcomes by facilitating earlier intervention and tailored therapeutic approaches for affected patients.
Preventive Measures Against Zoonotic Infections
Given the potential for zoonotic transmission of hemotropic mycoplasmas, establishing effective preventive measures becomes paramount, particularly for vulnerable populations such as immunocompromised patients. These measures include educating caregivers and family members on the signs of zoonotic diseases and implementing hygiene practices that mitigate transmission risks from pets. Routine health screenings for pet animals in households with immunocompromised individuals could also significantly reduce the likelihood of zoonotic infections.
In addition to educating individuals about pet care and hygiene, broader public health initiatives targeted at surveillance of zoonotic infections are crucial. This includes monitoring both animal and human populations for signs of hemoplasma presence and potential transmission routes. Ongoing research into the ecology of hemotropic mycoplasmas, particularly in bat populations, will further inform strategies to prevent zoonotic infections and protect at-risk groups, ensuring a multi-faceted approach to public health safety.
The Importance of Surveillance in Emerging Infections
The presence of hemotropic mycoplasmas in immunocompromised pediatric patients highlights a critical need for enhanced surveillance of emerging zoonotic infections. As more patients with weakened immune systems engage in activities involving animals or live in proximity to wildlife, the risk of encountering novel pathogens multiplies. This necessitates continuous observation and research to not only identify outbreaks but also to track potential zoonotic reservoirs that can impact human health.
Healthcare systems must adapt to include robust surveillance programs that leverage molecular diagnostics, such as real-time PCR. By implementing thorough screening processes and promoting awareness of zoonotic risks associated with hemotropic mycoplasmas and other emerging pathogens, we can better prepare for and respond to future infections. This vigilance is especially crucial in urban settings where wildlife interactions may go unnoticed, allowing for the effective monitoring of potential disease transmission pathways.
Implications for Pediatric Healthcare Providers
Healthcare providers caring for pediatric patients, especially those who are immunocompromised, must remain aware of the implications of hemotropic mycoplasmas. The atypical infections caused by these organisms may not only complicate the clinical picture but also necessitate a broader management strategy that includes avoiding potential zoonotic exposures. Pediatric care teams should be vigilant in monitoring for symptoms related to hemoplasmas and employ diagnostic tests such as real-time PCR promptly when these symptoms arise.
Furthermore, healthcare providers play a crucial role in guiding families on preventive measures, such as ensuring proper pet care and hygiene practices to mitigate risks of zoonotic infections. By fostering a comprehensive understanding of hemotropic mycoplasmas among physicians and families, we can create a proactive healthcare environment that prioritizes infection prevention and early detection strategies for immunosuppressed pediatric patients.
The Diagnostic Challenge of Hemoplasma Infections
The diagnostic challenge posed by hemotropic mycoplasma infections lies in their often subtle clinical manifestations and the complexity of differentiating them from other diseases, especially in immunosuppressed individuals. Symptoms such as fatigue, fever, and weight loss are common across many infectious states, potentially leading to misdiagnosis or delayed treatment. A heightened awareness of hemoplasmas, particularly in contexts involving zoonotic exposure, is crucial for accurate diagnosis.
Utilizing advanced diagnostic tools like real-time PCR adds a layer of sophistication to the identification of these infections, yet challenges remain. Clinicians must balance the interpretation of results and clinical context, as the presence of hemoplasmas may not always correlate with severe clinical disease. Continued education on the prevalence and risks associated with hemoplasma infections is key for improving diagnostic accuracy and patient outcomes in vulnerable populations.
Future Directions in Hemotropic Mycoplasma Research
Future research directions in the field of hemotropic mycoplasmas are essential for unveiling the complexities surrounding their transmission, diagnostics, and clinical implications. Investigations focusing on the ecological niche of these pathogens, particularly their relationship with bat populations, could provide invaluable insights into zoonotic transmission pathways. Additionally, understanding the genetic variations among hemoplasma strains may inform risk assessments and therapeutic strategies in clinical settings.
There is also a need for longitudinal studies that monitor the health outcomes of immunocompromised patients who have been exposed to hemoplasmas. These studies could elucidate the potential long-term impacts of infection and the effectiveness of diagnostic methods like real-time PCR in managing patient care. By pushing the boundaries of current research, the medical community can enhance our understanding of hemotropic mycoplasmas and develop targeted interventions to protect vulnerable individuals from these emerging zoonotic threats.
Frequently Asked Questions
What are hemotropic mycoplasmas and their significance in zoonotic diseases?
Hemotropic mycoplasmas, also known as hemoplasmas, are small, cell-wall deficient bacteria that can attach to red blood cells in animals and humans. They are significant in zoonotic diseases as they have been identified in various animal species and can potentially transmit to humans, particularly affecting immunosuppressed patients who are at a higher risk of severe disease, such as hemolytic anemia.
How do hemotropic mycoplasmas affect immunosuppressed patients?
In immunosuppressed patients, hemotropic mycoplasmas can lead to severe conditions such as hemolytic anemia. These patients might experience clinical symptoms, including fatigue, fever, and abdominal pain due to the compromised immune response, making them more susceptible to infections from zoonotic sources.
What evidence is there of hemotropic mycoplasmas being transmitted from bats to humans?
Molecular evidence has shown that certain strains of hemotropic mycoplasmas, specifically Candidatus Mycoplasma hematohominis, likely originating from bats, have been reported in human patients across various countries. This highlights the potential for zoonotic transmission, particularly in urban environments where wildlife interactions may be limited.
What role does real-time PCR play in the diagnosis of hemotropic mycoplasmas?
Real-time PCR is a crucial diagnostic tool for detecting hemotropic mycoplasmas. It allows for the identification of hemoplasma DNA in blood samples, enabling the diagnosis of infections in immunosuppressed patients and assessing the risk of associated hemolytic anemia.
Are hemotropic mycoplasmas a concern for pediatric patients undergoing immunosuppression?
Yes, hemotropic mycoplasmas are a pressing concern for pediatric patients undergoing immunosuppression due to conditions such as organ transplant or cancer treatment. In these patients, the risk of developing anemia and other symptoms associated with hemoplasma infections increases, necessitating careful monitoring and research into potential zoonotic transmission pathways.
What can be done to enhance surveillance for hemotropic mycoplasmas in immunocompromised individuals?
To enhance surveillance for hemotropic mycoplasmas, it is essential to implement routine screening for these pathogens in immunocompromised populations, particularly those who have pets or live in urban areas with possible bat exposure. Increased awareness among healthcare providers and the public about the risks of zoonotic infections can also aid in early detection and management.
| Key Point | Details |
|---|---|
| Detection of Hemotropic Mycoplasmas | Identified in 4 immunosuppressed pediatric patients in Spain. |
| Origin and Similarity | The sequences were identical to a strain from bats (Miniopterus schreibersii). |
| Impact on Immunocompromised Patients | Hemotropic mycoplasmas can cause hemolytic anemia, particularly in immunocompromised hosts. |
| Human Cases and Risks | Cases reported with species like Candidatus Mycoplasma hematominutum, linked to zoonotic exposure. |
| Clinical Symptoms | Symptoms include anemia, fever, asthenia, abdominal pain, and weight loss. |
| Study Methodology | Analyzed 69 blood samples using PCR targeting the hemoplasma 16S rRNA gene. |
| Study Findings | Four out of 69 samples tested positive; no zoonotic transfer from pets found. |
| Need for Further Investigation | Urban living with no wildlife contact raises questions about domestic reservoirs. |
Summary
Hemotropic mycoplasmas represent a critical concern in immunocompromised populations, as highlighted by a recent study reporting their detection in pediatric patients in Spain. These unique, cell-wall deficient bacteria have potential zoonotic origins, particularly from bat species. The clinical implications of hemotropic mycoplasmas include risks of hemolytic anemia and associated symptoms that can further complicate the health of vulnerable patients. Given the absence of wildlife exposure in the affected urban participants, there is a pressing need for enhanced surveillance and research to explore the domestic pathways of transmission and the role of potential reservoirs in this emerging health concern.
The content provided on this blog (e.g., symptom descriptions, health tips, or general advice) is for informational purposes only and is not a substitute for professional medical advice, diagnosis, or treatment. Always seek the guidance of your physician or other qualified healthcare provider with any questions you may have regarding a medical condition. Never disregard professional medical advice or delay seeking it because of something you have read on this website. If you believe you may have a medical emergency, call your doctor or emergency services immediately. Reliance on any information provided by this blog is solely at your own risk.